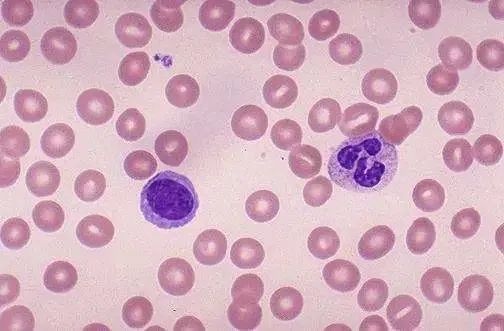
640 (4).jpg

- 玉中科普
“痰”吐不凡 | 不同顏色的痰提示什么?。柯牂z驗(yàn)科醫(yī)生談一“痰”
小時(shí)候?qū)W習(xí)基本道德規(guī)范時(shí)
我們就被告誡不能隨地吐痰,
原因是不文明。
學(xué)了一些醫(yī)學(xué)知識(shí)以后
覺得更不能隨地吐痰,
因?yàn)椤疤怠闭娴牟黄椒玻?/p>
它雖然藏污納垢,
卻能有效地提示許多疾病的病因。
痰是人體呼吸道粘膜產(chǎn)生的分泌物,主要功能是保持呼吸道濕潤(rùn),正常人痰很少。當(dāng)呼吸道受刺激,比如病原菌感染時(shí),痰液會(huì)分泌得更多,以更好地粘附、清除這些病原菌,此時(shí)痰可由少許黏液痰變成大量膿痰。
不同病原體感染后痰液顏色往往有所不同
白色的粘痰
表示呼吸道有輕微的炎癥,常是感冒的患者。痰白黏稠且呈拉絲狀,提示有真菌感染。
在電子顯微鏡下,會(huì)看到許多白細(xì)胞和各種類型的感冒病毒。如果真菌感染則會(huì)看到真菌孢子或菌絲。
黃色或綠色的濃痰

大多是由于干酪樣肺炎、肺結(jié)核,以及綠膿桿菌引起的肺炎、肺膿腫、支氣管擴(kuò)張等疾病。膿液為死亡的白細(xì)胞、壞死組織,要注意與肺炎鏈球菌引起的大葉性肺炎區(qū)別。
灰色或黑色的痰
多是因?yàn)槲氪罅炕覊m或長(zhǎng)期吸煙,以及長(zhǎng)期接觸碳粉、煤塵等導(dǎo)致。這種痰常出現(xiàn)在職業(yè)病的患者,特別是生活在多煙、炭塵中的煤炭、鍋爐工人。平時(shí)都要佩戴防塵口罩,吸煙人群最好戒煙。
粉紅色
通常粉紅色泡沫樣痰被視為急性肺水腫的典型表現(xiàn),患者還會(huì)伴隨煩躁不安、大汗淋漓、嚴(yán)重的呼吸困難和劇烈的咳嗽,甚至出現(xiàn)端坐呼吸。多在夜間或勞累后咳出粉紅色泡沫樣痰,還有可能是由于胃酸引起的食管損傷破壞。
帶血絲的痰
痰中帶紅色血絲,多見于肺結(jié)核或支氣管擴(kuò)張,平時(shí)咽部有炎癥、上呼吸道出血、大葉性肺炎初期也可能會(huì)出現(xiàn)這種情況。紅色或暗紅色血樣痰,可能是由于出血性疾病、呼吸道或血管損傷、支氣管肺癌、肺結(jié)核空洞、支氣管擴(kuò)張等疾病引起。
鐵銹色
如果出現(xiàn)鐵銹色痰,而且病前有上呼吸道感染、受涼、淋雨,且伴隨高熱、喘促、惡寒、胸悶、胸痛等癥狀,則多數(shù)直接考慮是肺炎鏈球菌肺炎,又稱為大葉性肺炎。(常在發(fā)病24~48 h出現(xiàn)銹色痰)
磚紅色膠凍樣痰
患者出現(xiàn)磚紅色膠凍狀痰,可能是克雷伯桿菌肺炎,出現(xiàn)了多發(fā)性蜂窩狀肺膿,常伴有寒顫、高熱及全身衰竭。
所以,平時(shí)在吐痰時(shí)可以多留意下,看看是否有以上顏色的痰液。一旦發(fā)現(xiàn)痰的顏色、性狀、味道、量等方面發(fā)生改變的,都要及時(shí)就醫(yī)檢查,并做相應(yīng)治療,一般痰多超過兩周就應(yīng)當(dāng)就診。
一般在哪些情況下建議到醫(yī)院做痰培養(yǎng)?
1.有咳嗽、咳痰,痰液顏色為鐵銹色、紅棕色,痰液性狀呈膿性、血性或膠凍樣;
2.咯血,包括泡沫血痰、鮮血和痰中帶血等;
3.呼吸困難,呼吸急促或哮喘,常伴有胸痛時(shí);
4.發(fā)燒,抽血化驗(yàn)提示白細(xì)胞增高尤其是中性粒細(xì)胞或CRP、PCT明顯增高;

5胸部影像學(xué)檢查提示有感染可能,肺部感染的患者有25-50%可能會(huì)發(fā)生菌血癥(指細(xì)菌入血),痰液不是確定細(xì)菌性肺炎病原體的最佳標(biāo)本。血液、肺泡灌洗液標(biāo)本或經(jīng)氣管抽吸的標(biāo)本可能更準(zhǔn)確。
